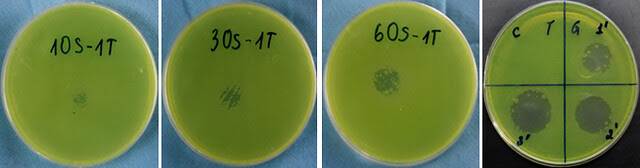

Lưu trữ danh mục: Tin công ty
PLASMA VIỆT NAM tham gia Triển lãm quốc tế Đổi mới sáng tạo Việt Nam 2023
Từ ngày 28/10 đến ngày 01/11/2023, tại NIC Cơ sở Hòa Lạc đã diễn ra...
03
Th11
Th11
Công ty CP Công nghệ Plasma Việt Nam Tham gia hội chợ Techfest Hà Nội 2023
Công Ty Cổ Phần Công Nghệ Plasma Việt Nam đã tham gia tổ chức gian...
14
Th10
Th10
HỘI THẢO: TĂNG CƯỜNG CÔNG TÁC QUẢN LÝ KHOA HỌC VÀ CÔNG NGHỆ NGÀNH Y TẾ
Sáng ngày 02/12/2022 tại Hà Nội, Bộ Y tế tổ chức hội thảo “Tăng cường...
06
Th12
Th12
Bệnh viện T.Ư Huế: Điều trị bệnh nhân Covid-19 bằng công nghệ plasma lạnh
Trung tâm ICU người bệnh Covid-19, Bệnh viện T.Ư Huế tại TPHCM, đã ứng dụng...
05
Th1
Th1
Tác dụng diệt khuẩn của tia plasma lạnh hồ quang trượt
Một thí nghiệm do các nhà khoa học của ARIPT thực hiện trên môi trường...
1 Bình luận
05
Th1
Th1
Điều trị Eczema bằng plasma lạnh
Một nghiên cứu lâm sàng được thực hiện trên một bệnh nhân mắc Eczema thể...
05
Th1
Th1

 English
English